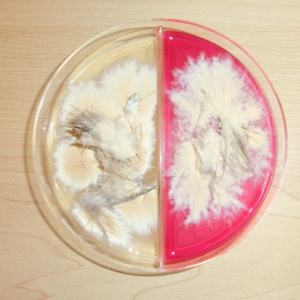

仔猫のカビの感染(皮膚糸状菌症)

仔猫のカビの感染
- 抵抗力の弱い仔猫の皮膚に水虫の仲間の皮膚糸状菌が感染する皮膚病です。
- 円形の脱毛が特徴的です。
- 仔猫で体のあちこちに脱毛が起こるとまずこの病気を疑います。
![]() |
|
仔猫のカビの感染の症状
- 円形の脱毛。
- 重度の場合、白い痂皮(かさぶた)。
- 全身に感染する。
- 通常痒み(かゆみ)はない。
- 初期は痒みがなく、重度になると痒みが出てくる場合があります。
仔猫のカビの感染の検査
- 真菌培養
- ウッド灯
真菌培養
白い綿状のカビが生えてきて培地が赤く変色すれば皮膚糸状菌であることが分かります。
仔猫のカビの感染の治療
- 抗真菌薬
- シャンプー …毎日、全身に行いカビ(=真菌)の増殖を防ぎます。
- 外用剤(塗り薬)…脱毛部位へ
- 内服 …肝臓への悪影響を考慮し、仔猫ではなるべく使用を控えます。
- ※治療の中心はシャンプーです。毎日すれば1~2週間でかなり良くなります。




